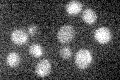

View description
Transcriptional corepressor involved in repression of ribosomal protein (RP) gene transcription via the TOR signaling pathway which promotes accumulation of Crf1p in the nucleus; role in repression of RP genes varies by strain
Localization:
Intensity:
Fold change:
Significance:
-
C’ GFP library in SD

below threshold15.41 -
N' NOP1pr-GFP in SD

cytosol,nucleus38.8496 -
N' TEF2pr-mCherry in SD

missing0 -
N' NATIVEpr-GFP in SD

punctate22.4298 -
N' TEF2pr-VC and Cyto-VN in SD

#N/A0 -
C’ GFP library in SD+DTT

cytosol19.231.24No -
C’ GFP library in SD+H2O2

cytosol17.361.12No -
C’ GFP library in Starvation Media
cytosol14.570.94No -
C’ GFP library on the background of Pup2-DaMP

below threshold -
C’ GFP library on the background of CCT mutant

below threshold17.47881.13349No
